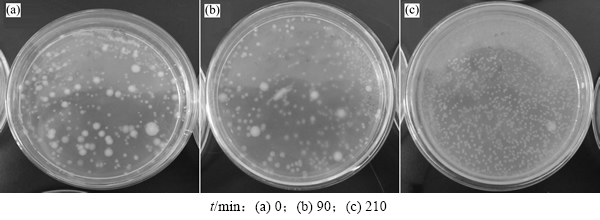

DOI: 10.11817/j.issn.1672-7207.2016.05.003
微生物诱导下甲烷厌氧氧化及碳酸盐矿物生成实验
刘肖,许天福,魏铭聪,温玉娟,金光荣,曹玉清
(吉林大学 地下水资源与环境教育部重点实验室,吉林 长春,130021)
摘要:从淤泥样品中,培育甲烷氧化菌并对其进行DNA测序;进而在自行研制的反应系统中开展甲烷氧化菌-水-岩石相互作用实验,检测微生物的数量和HCO3-质量浓度的变化,最后对岩石样品进行扫描电镜分析。研究结果表明:所培养的淡水甲烷氧化菌为假单胞菌属;微生物注入反应器后有HCO3-的生成,HCO3-质量浓度变化与微生物数量和活性有关;石英砂表面生成无定形铁白云石、亮白色菱柱状碳酸盐和长石类矿物的中间产物。
关键词:甲烷氧化菌;甲烷厌氧氧化;碳酸盐矿物
中图分类号:P593 文献标志码:A 文章编号:1672-7207(2016)05-1473-07
Experiment on anaerobic oxidation of methane and precipitation of carbonate mediated by microbes
LIU Xiao, XU Tianfu, WEI Mingcong, WEN Yujuan, JIN Guangrong, CAO yuqing
(Key Laboratory of Groundwater Resources and Environment, Ministry of Education, Jilin University, Changchun 130021, China)
Abstract: The methane oxidizing bacteria was isolated from lake bottom sediment and the corresponding DNA sequencing was carried out. Experiment of interaction between methane oxidizing bacteria-water-rock was conducted in a self-developed reactor system, and variations of the number of microorganisms and the mass concentration of HCO3- were analyzed, respectively. Finally, rock slices were viewed with scanning electron microscope (SEM). The results show that the cultured methane oxidizing bacteria belongs to pseudomonas genus. HCO3- produced after bacteria injected into the reactor. Changes of mass concentration of HCO3- have certain correlation relationship with the number and microbial activity of microorganism. Intermediate minerals, including amorphous ankerite, bright columnar of carbonate and feldspars, are precipitated on the surface of quartz sandstone.
Key words: methane oxidizing bacteria; anaerobic oxidation of methane; carbonates
甲烷是一种重要的温室气体,从生态学的角度分析,自然界中广泛存在产甲烷菌,有机物被不断地降解释放甲烷[1],甲烷在大气中的停留时间大约为7.9 a[2-3],对全球气候变暖的影响是二氧化碳的25倍[1-3]。而厌氧的海洋沉积物作为地球上最大的甲烷储层,其中的甲烷或溶解在沉积物孔隙水中并向海底渗漏,或在适合的温度压力和地质条件下形成天然气水合 物[4],海洋沉积物的甲烷生成率为(85~300)×1012 g/a[5-7],若甲烷释放到大气中,则将严重加剧温室效应。但实际监测结果显示,产于海洋沉积物的甲烷对总甲烷气体释放量的贡献较小(~2%)[7-8];同时联合国环境保护署2010年的研究报告也显示,占全球总面积71%的海洋对大气圈自然排放甲烷总量的贡献仅为3.5%[9],该控制甲烷气体释放的现象是由于海洋沉积物产生的大量甲烷向海底泄漏(或运移)过程中被沉积物中厌氧生物所消耗,发生甲烷厌氧氧化反应(anaerobic oxidation of methane, AOM)[5],并转化为碳酸盐[9]导致的。大量海洋地质调查获得的同位素分馏特征等地球化学数据表明[5, 10]:甲烷厌氧氧化(AOM)反应普遍存在,通常发生在冷泉区、泥火山和天然气水合物储层上方等富甲烷流体渗漏逃逸的地方。在AOM区中,海底甲烷分别在甲烷氧化细菌和硫酸盐还原细菌2种微生物的协同作用下[11-13],发生如下反应:CH4+SO42-→HCO3-+HS-+H2O,其中的甲烷作为电子供体,硫酸盐作为电子受体,生成的重碳酸根可与地层中的阳离子反应生成碳酸盐矿物[14-15]。甲烷厌氧氧化(AOM)消耗海洋沉积物产生的甲烷,并可将其转化为碳酸盐岩矿物保存下来,故研究甲烷厌氧氧化机理及其诱导下的矿物生成机制对了解其在全球碳循环和全球气候变化的作用以及由甲烷气泄漏引起的环境效应的研究中均有着重要的意义。近年来,有关AOM的研究越来越多,但实验室内关于AOM的研究多是用于确定其生物机理[16]、甲烷厌氧氧化速 率[17-18]或者其同位素分馏特征[19]。如KNITTEL等[16]对甲烷厌氧氧化反应的速率、环境影响因素以及ANME的作用机制进行了介绍;NAUHAUS等[17-18]对甲烷厌氧氧化反应的速率进行了研究,结果显示在不同的甲烷分压情况下,AOM的反应速率可差几个数量级。梁洪野等[20-21]也进行了甲烷氧化菌的分离鉴定相关工作,其初衷多是进行淡水环境下甲烷氧化菌快速、高密度培养[20]以便应用在工业生物催化中或者降解污水中的三氯甲烷、三氯乙烯等有毒卤代烃和多环芳烃[21-22];近年来,国内也开展了部分关于海洋环境中微生物方面的研究[23],但仍然处于起步阶段。而在实验室条件下有关AOM的矿物生成机制以及其与生物活动间关系的报道较少,关于生物活动与矿物沉积间机理仍然不清楚。CHEN等[24]观察到AOM过程中的细胞微生物团被硅酸盐包裹,并提出了AOM生物团的矿物生成机制。因此,研究海底甲烷渗漏背景下的甲烷厌氧氧化诱导的矿物形成机制十分必要。本文作者采用实验室内微生物培育技术、水化学分析以及矿物表面形态观察和成分分析等方法,获得甲烷-微生物实验的微生物、水化学、矿物组分结果,探讨AOM过程中微生物生长以及水化学变化、矿物形成的机理。
1 实验
1.1 样品采集
甲烷氧化菌广泛分布于湖泊、沼泽、海底中,而海底底泥样品不易取得,故为了便于实验,本次采集长春某湖底淤泥样品培养甲烷氧化菌。
1.2 甲烷氧化菌培养
分别称取淤泥样品5 g,置于已灭菌并加入液体培养基(表1)100 mL的锥形瓶中,用锡箔纸封口。用100 mL无菌注射器充入甲烷气体(甲烷气体购于大连气体厂,纯度为99.99%),放置在30 ℃、转速为110 r/min的震荡培养箱中,培养6 d直到培养液混浊,得到微生物的母液,期间每隔1 d充1次甲烷气体。为了使微生物更好地适应富含甲烷的环境,逐渐增加充入的甲烷气体量。作为空白对照的锥形瓶中,仅加入液体培养液和甲烷气体进行培养,不添加淤泥样品。
表1 培养基的成分(质量浓度)
Table 1 Composition of culture medium g/L

为了得到纯度更高的微生物菌液,取20 mL已培养6 d的培养液上清液接种于新鲜培养基中,相同条件下培养6 d至培养液混浊,重复培养多次,培养期间逐渐加大充入的甲烷气体量,获得纯度较高的微生物菌液。
通过母液的培养、传代以及纯化等步骤,得到了能够利用甲烷进行生长的菌液。空白样培养液清澈透明,说明培养出的菌量很少,可认为几乎没有,其他的培养液混浊,说明培养的微生物为甲烷氧化菌。
1.3 菌种鉴定
为了进一步确定所培养的微生物为甲烷氧化菌,本次实验进行了菌种的分子生物学鉴定。采用平板涂布法(表1)对甲烷氧化菌进行纯种分离,待菌落生长后挑取单菌落采用划线平板法分离纯化,获得优势菌株,并邮寄至上海生工进行分子生物学鉴定。甲烷氧化菌的DNA提取使用UNIQ-10柱式细菌基因组DNA抽提试剂盒(上海生工),提取流程按照DNA提取盒的说明进行。用细菌16S rDNA通用引物27F(5’-AGTTTGATCMTGGCTCAG-3’)和1492R(5’-GGTTACCTTGTTACGACTT-3’)扩增16S rDNA片段。PCR体系选用25 μL反应体系:基因组DNA(20~50 mg/L)0.5 μL;5×PCR缓冲液2.5 μL;dNTP(各2.5 mmol/L) 1 μL;F(10 μmol/L) 0.5 μL;R(10 μmol/L) 0.5 μL;ddH2O补足体积。在PCR仪上进行扩增,条件为:98 ℃预变性3 min;98℃时进行25 s,55℃时进行25 s,72℃时进行1 min,30个循环;72℃修复延伸10 min;4℃保存。根据获得的16S rDNA序列,采用BLAST对菌种的DNA序列进行同源性对比,获知其菌种属性。
1.4 微生物-水-岩石-甲烷相互作用实验
1.4.1 实验装置
实验在自行研制的多功能水合物模拟实验系统(图1)中进行,该系统专为微生物-水-岩石-甲烷相互作用及其次生矿物生成实验设计。系统由供气、微生物注入、反应釜、控温、数据采集等子系统构成,反应釜的结构采用快开式以方便拆卸,反应釜内径为80 mm,高为200 mm,有效体积为1 000 mL,耐压值为25 MPa。釜体安装热电阻温度传感器和压力传感器。温度传感器(Pt100)探针伸入到釜体液面(溶液)中20 mm,精度为±0.1℃。压力传感器最大量程为40 MPa,精度为±0.25%,并配有压力表以方便观察,实验过程中的温度和压力变化由数据采集系统自动记录。实验时反应釜内分为饱水的砂、水、气三层,由微生物注入系统向低温高压反应釜中注入甲烷氧化菌,实验过程中取水样测试HCO3-等的变化以探究甲烷氧化机理。

图1 高压反应釜实验装置示意图
Fig. 1 Schematic diagram of experimental device of high pressure reactor
1.4.2 实验条件
根据GUAN等[25]的研究,甲烷厌氧氧化可发生在水合物储层上方、泥火山等甲烷渗漏区,其在水深约470 m到大于3 000 m的海底均有发现,其相应的温度在0~8 ℃之间,温度相对较低;相应的压力在4.0~30.0 MPa间变化。因此,在现有的条件下,本文开展了2组微生物-水-岩石-甲烷相互作用实验,在固定实验温度为1.8 ℃条件下,分别进行了压力为4.5和7.0 MPa的2组实验。
1.4.3 实验步骤及测试分析
在将培养好的菌液注入反应釜前,选择生长好的甲烷氧化菌进行扩增、浓缩后用紫外分光光度计(UV2100,尤尼科(上海)仪器有限公司)调节甲烷氧化菌菌液的光密度(OD)为1(OD为被检测物吸收掉的光密度,能够定性表征甲烷氧化菌菌液的浓度,本次实验在600 nm下测定)。将OD为1的甲烷氧化菌菌液50 mL注入到微生物容器(图1)中,通过平流泵将微生物容器中的微生物菌液注入到反应釜中。注入后,取液体样,分别进行HCO3-质量浓度的测定和甲烷氧化菌的平板计数。HCO3-质量浓度的测定采用酸碱中和滴定法测试,单位为mg/L;而甲烷氧化菌的平板计数采用涂布平板法,单位为个。在实验结束后,将岩石样品烘干并进行扫描电镜分析,岩石片的表面形态观察在吉林大学古生物中心实验室中进行,利用配置的JSM-6700F型扫描电镜(scanning electron microscope, SEM, JEOL Corporation, Tokyo, Japan)和INCAX-SIGHT型能谱仪(energy-dispersive X-ray spectrometer, EDS, Oxford, UK)进行表面形态观察和矿物成分分析。
2 实验结果与分析
2.1 微生物鉴定结果
由菌落微生物提取的总DNA在凝胶成像系统下拍照结果可知:各菌落均得到1条较为清晰的电泳条带,说明其基因组DNA提取有效。对以上DNA进行PCR扩增,结果如图2所示。与Marker比较可知,扩增后各菌落微生物的基因片段约为1 400 bp。
利用菌落的DNA序列采用BLAST进行同源性序列对比:图中S1408菌属于假单胞菌属,与假单胞菌fluorescens strain LMG 14576 16S同源性为100%;S1409菌属于假单胞菌属,与假单胞菌putida H8234菌株序列同源性为99%;S1410菌属于不动杆菌属,与不动杆菌属calcoaceticus strain YLZZ-1 16S同源性为99%;S1411菌属假单胞菌属,与假单胞菌fluorescens strain LMG 14576 16S同源性为99%;由此判定所培养的微生物为假单胞菌属的甲烷氧化菌。

图2 各菌落16S rDNA PCR 扩增产物琼脂糖电泳
Fig. 2 Agarose gel electrophoresis of PCR amplified 16S rDNA for different samples
2.2 微生物-水-岩石-甲烷相互作用结果
微生物注入后实验过程中HCO3-质量浓度随时间的变化如图3(a)和4(a)所示。由图3(a)和4(a)可以看出:甲烷氧化菌菌液注入后,其t=0时刻的HCO3-质量浓度为注入菌液中含有的HCO3-被稀释的结果,HCO3-质量浓度初始时刻背景值分别为23 mg/L和10 mg/L,而微生物注入后的微生物数量背景值分别为1.45×106和1.70×106个;甲烷氧化菌在饱和甲烷的反应釜中生长,代谢产生HCO3-,HCO3-质量浓度增加,4.5 MPa(实验1)时,HCO3-质量浓度最高约47 mg/L,7.0 MPa(实验2)时最高能达到49 mg/L;随后HCO3-质量浓度降低,接近但高于其初始质量浓度。
从图3(a)可以看出:HCO3-质量浓度随时间呈现先增加(0~90 min)后减小(90~150 min)的趋势。反应液中HCO3-质量浓度的变化是微生物-甲烷相互作用的结果,注入的甲烷氧化菌利用甲烷单加氧酶氧化反应釜内的甲烷气,发生的反应式为:CH4+3H2O→ HCO3-+4H2+H+,产生HCO3-,这个反应是由微生物引起的反向甲烷生成反应[26-28],从热力学角度来说是可以实现的[27]。微生物注入后,微生物需适应反应釜中的新环境,原菌液中营养物质充分,部分微生物活性较高;且微生物在适应新环境过程中不断地代谢产生HCO3-,HCO3-质量浓度增加,在90 min时HCO3-质量浓度达到最大值47.65 mg/L。而在适应新环境的过程中,部分微生物不能适应新环境而导致生物活性受到抑制或死亡,微生物数量降低,90 min时微生物的数量最小达到9.30×105个(图3(b))。微生物在适应了新环境后,利用原有菌液中的营养物质生长,微生物数量增加到2.75×106个(90~150 min)。随后由于HCO3-与溶液中的某些阳离子结合生成沉淀消耗HCO3-,消耗量大于微生物作用下甲烷厌氧氧化反应生成的量,因此,HCO3-质量浓度在逐渐减小。由于实验1时间较短,150 min时的HCO3-质量浓度为 29.32 mg/L,比初始时刻的23.46 mg/L高出5.86 mg/L。因此,在实验2时加长了微生物与甲烷相互作用的时间,以期获得效果更好的HCO3-质量浓度变化数据。

图3 4.5 MPa时HCO3-质量浓度和微生物数量随时间的变化
Fig. 3 Changes of mass concentration of HCO3- and microbial quantity over time at 4.5 MPa
从图4(a)可以看出:HCO3-质量浓度随时间也是先增加(0~90 min)后减小(90~1 170 min)的趋势,在 90 min时HCO3-质量浓度达到最大值48.45 mg/L。同实验1,此时的微生物最活跃,对应图4(b)中微生物数量最少。微生物在适应了环境的过程中,利用原有菌液中的营养物质生长,微生物数量增加到2.85×106个(150~210 min间)。210 min后,微生物继续利用反应釜内的营养物质生长,微生物的数量超过3.00×106个,无法计数,但是能看出微生物数量增加。在1 170 min时,检测溶液中HCO3-质量浓度降为4.39 mg/L,这是HCO3-与溶液中的某些阳离子结合生成沉淀所造成的。

图4 7.0 MPa时HCO3-质量浓度和微生物数量随时间的变化
Fig. 4 Changes of mass concentration of HCO3- and microbial quantity over time at 7.0 MPa
2次不同压力下的实验显示:微生物在不同压力下的HCO3-质量浓度均呈先增加后减小的趋势,达到HCO3-质量浓度峰值点所需的时间基本一致。HCO3-质量浓度最高的时候是微生物个数最低的时候,HCO3-质量浓度的增大和减小能够表征微生物的生长及其活性衰减情况。在整个甲烷厌氧氧化反应发生的过程中,微生物不断的适应新环境,从初始时刻到实验结束时,微生物的形态发生了改变(图5),微生物菌落的形态由开始的直径3 mm左右的圆形菌转变为后期的1 mm左右的圆形菌居多。其中的甲烷氧化菌为甲烷的氧化提供动力,促使甲烷厌氧氧化反应的发生。
实验结束后,在石英砂表面发现了含Ca,Fe和Mg的碳酸盐矿物。典型的碳酸矿物照片如图6(a)和6(b)所示,其中图6(a)所示为团状的无定形矿物,含Mg,Ca,Fe,Na,Si,C和O等组分(图6(c)),推断为铁白云石。而实验所用石英砂主要含石英和长石类矿物,因此扫描电镜结果所含的Al和Si为背景矿物所含组分。而图6(b)所示为亮白色菱柱状矿物,含Mg,Ca,Fe,Na,Si,C和O等组分(图6(d)),推断为碳酸盐矿物和长石类矿物的中间产物。
基于现有的实验结果,结合CHEN等[24]关于甲烷厌氧氧化的研究成果,将甲烷厌氧氧化中微生物的活动以及矿物沉积间的关系表示如图7所示。由于甲烷氧化菌的代谢作用,反应釜中的甲烷被微生物利用,发生甲烷厌氧氧化反应,生成了HCO3-,导致溶液碱度增加,HCO3-与溶液中的阳离子结合,发生反应:HCO3-+Ca2+(Mg2+, Fe2+)→CaCO3(MgCO3, FeCO3)+H+,生成碳酸盐矿物。
图5 平板计数照片
Fig. 5 Photos of plate count

图6 扫描电镜观察结果
Fig. 6 Results from SEM observation

图7 甲烷氧化菌与碳酸盐矿物沉淀的关系[24]
Fig. 7 Relationship between microbial metabolism and precipitation of carbonate[24]
3 结论
1) 本室内实验培养的甲烷氧化菌为假单胞菌属,可利用甲烷作为碳源生长。
2) 微生物注入反应釜后,甲烷被消耗,发生了甲烷厌氧氧化反应CH4+3H2O→HCO3-+4H2+H+,实验获得的HCO3-质量浓度变化与微生物数量和活性有关。HCO3-的这种变化趋势间接地表征微生物的生长和活性衰减情况。
3) 甲烷氧化菌注入低温、高压条件的反应器后,需要一定时间适应新的环境,适应环境后,微生物数量增加;但后期因营养物质得不到补充,甲烷氧化菌生物活性衰减。
4) 在甲烷氧化细菌的作用下,石英砂表面生成了无定形铁白云石以及亮白色菱柱状碳酸盐和长石类矿物的中间产物,印证了甲烷厌氧氧化反应的发生。
参考文献:
[1] 韩冰. 甲烷氧化菌的微生态解析及其应用基础研究[D]. 北京: 清华大学化学工程系, 2008: 3-23.
HAN Bing. Molecular ecology study on methanotrophs and fundermantal research on the applications of methanotrophs[D]. Beijing: Tsinghua University. Department of Chemical Engineering, 2008: 3-23.
[2] 陈忠, 颜文, 陈木宏, 等. 海底天然气水合物分解与甲烷归宿研究进展[J]. 地球科学进展, 2006, 21(4): 394-400.
CHEN Zhong, YAN Wen, CHEN Muhong, et al. Advances in gas hydrate dissociation and fate of methane in marine sediment[J]. Advances in Earth Science, 2006, 21(4): 394-400.
[3] LELIEVELD J O S, CRUTZEN P J, DENTENER F J. Changing concentration, lifetime and climate forcing of atmospheric methane[J]. Tellus B, 1998, 50(2): 128-150.
[4] DALE A W, VAN CAPPELLEN P, AGUILERA D R, et al. Methane efflux from marine sediments in passive and active margins: estimations from bioenergetic reaction-transport simulations[J]. Earth and Planetary Science Letters, 2008, 265(3): 329-344.
[5] LIU L, WU N. Simulation of advective methane flux and AOM in Shenhu area, the northern South China Sea[J]. Environmental Earth Sciences, 2014, 71(2): 697-707.
[6] KNITTEL K, BOETIUS A. Anaerobic oxidation of methane: progress with an unknown process[J]. Annual Review of Microbiology, 2009, 63: 311-334.
[7] REEBURGH W S. Oceanic methane biogeochemistry[J]. Chemical Reviews, 2007, 107(2): 486-513.
[8] REEBURGH W S. Global methane biogeochemistry[J]. Treatise on Geochemistry, 2003, 4: 65-89.
[9] ANDERSON B, BARTLETT K, FROLKING S, et al. Methane and nitrous oxide emissions from natural sources[R]. Washington: United States Environmental Protection Agency, Office of Atmospheric Programs, 2010: 1-194.
[10] REEBURGH W S. Methane consumption in Cariaco Trench waters and sediments[J]. Earth and Planetary Science Letters, 1976, 28(3): 337-344.
[11] BOETIUS A, RAVENSCHLAG K, SCHUBERT C J, et al. A marine microbial consortium apparently mediating anaerobic oxidation of methane[J]. Nature, 2000, 407(6804): 623-626.
[12] HINRICHS K U, HAYES J M, SYLVA S P, et al. Methane- consuming archaebacteria in marine sediments[J]. Nature, 1999, 398(6730): 802-805.
[13] ORPHAN V J, HOUSE C H, HINRICHS K U, et al. Methane-consuming archaea revealed by directly coupled isotopic and phylogenetic analysis[J]. Science, 2001, 293(5529): 484-487.
[14] KOCHERLA M. Authigenic gypsum in gas-hydrate associated sediments from the east coast of India (bay of bengal)[J]. Acta Geologica Sinica, 2013, 87(3): 749-760.
[15] SUN Z L, WEI H L, ZHANG X H, et al. A unique Fe-rich carbonate chimney associated with cold seeps in the Northern Okinawa Trough, East China Sea[J]. Deep Sea Research Part Ⅰ: Oceanographic Research Papers, 2015, 95: 37-53.
[16] KNITTEL K, BOETIUS A. Anaerobic oxidation of methane: progress with an unknown process[J]. Annual review of microbiology, 2009, 63: 311-334.
[17] NAUHAUS K, BOETIUS A, KR
GER M, et al. In vitro demonstration of anaerobic oxidation of methane coupled to sulphate reduction in sediment from a marine gas hydrate area[J]. Environmental Microbiology, 2002, 4(5): 296-305.
[18] ZHANG Y, HENRIET J P, BURSENS J, et al. Stimulation of in vitro anaerobic oxidation of methane rate in a continuous high-pressure bioreactor[J]. Bioresource Technology, 2010, 101(9): 3132-3138.
[19] DEUSNER C, HOLLER T, ARNOLD G L, et al. Sulfur and oxygen isotope fractionation during sulfate reduction coupled to anaerobic oxidation of methane is dependent on methane concentration[J]. Earth and Planetary Science Letters, 2014, 399: 61-73.
[20] 梁洪野. 甲烷氧化菌的高密度培养[D]. 哈尔滨: 哈尔滨商业大学食品工程学院, 2011: 1-6.
LIANG Hongye. High cell density cultivation of methanotrophic bacteria[D]. Harbin: Harbin University of Commerce. College of Food Engineering, 2011: 1-6.
[21] 王晓丽, 于建国. 一个甲烷氧化菌株的分离, 鉴定及其特性研究[J]. 微生物学通报, 2008, 35(6): 934-938.
WANG Xiaoli, YU Jianguo. Isolation, identification and characterization of a methanotrophic strain[J]. Microbiology, 2008, 35(6): 934-938.
[22] 梁战备, 史奕, 岳进. 甲烷氧化菌研究进展[J]. 生态学杂志, 2004, 23(5): 198-205.
LIANG Zhanbei, SHI Yi, YUE Jin. The research progress of Methane oxidizing bacteria[J]. Chinese Journal of Ecolog, 2004, 23(5): 198-205.
[23] 史春潇, 雷怀彦, 赵晶, 等. 南海北部九龙甲烷礁邻区沉积物层中垂向细菌群落结构特征研究[J]. 沉积学报, 2014, 32(6): 1072-1082.
SHI Chunxiao, LEI Huaiyan, ZHAO Jing, et al. Vertical microbial community structure characteristics of sediment in gas hydrate potential area of Northern South China Sea Jiulong Methane Reef[J]. Acta Sedimentologica Sinica, 2014, 32(6): 1072-1082.
[24] CHEN Y, LI Y L, ZHOU G T, et al. Biomineralization mediated by anaerobic methane-consuming cell consortia[J]. Scientific Reports, 2014, 4(4): 5696.
[25] GUAN H, SUN Y, ZHU X, et al. Factors controlling the types of microbial consortia in cold-seep environments: a molecular and isotopic investigation of authigenic carbonates from the South China Sea[J]. Chemical Geology, 2013, 354: 55-64.
[26] HANSEN L B, FINSTER K, FOSSING H, et al. Anaerobic methane oxidation in sulfate depleted sediments: effects of sulfate and molybdate additions[J]. Aquatic Microbial Ecology, 1998, 14(2): 195-204.
[27] HEIJS S K, ALOISI G, BOULOUBASSI I, et al. Microbial community structure in three deep-sea carbonate crusts[J]. Microbial Ecology, 2006, 52(3): 451-462.
[28] PAPE T, BLUMENBERG M, SEIFERT R, et al. Marine methane biogeochemistry of the Black Sea: a review[C]// Links between Geological Processes, Microbial Activities & Evolution of Life. Netherlands: Springer, 2008: 281-311.
(编辑 杨幼平)
收稿日期:2015-05-21;修回日期:2015-07-16
基金项目(Foundation item):中国博士后面上基金资助项目(2015M571369);吉林大学研究生创新基金资助项目(2014104) (Project(2015M571369) supported by the Postdoctoral Science Foundation of China; Project(2014104) supported by the Graduate Innovation Fund of Jilin University)
通信作者:许天福,博士,教授,从事海洋天然气水合物试开采优化和相关自生矿物形成、地热能开发与利用等研究;E-mail: Tianfu_Xu@jlu.edu.cn